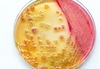

Estrutura bacteriana Flashcards
(46 cards)
Microbiologia: Estrutura bacteriana
As bactérias são classificadas como _________ (unicelulares/pluricelulares).
Unicelulares.
Microbiologia: Estrutura bacteriana
São seres _________ (eucariotos/procariotos).
Procariotos.
Microbiologia: Estrutura bacteriana
As bactérias pertencem ao reino…
monera.

Microbiologia: Estrutura bacteriana
V ou F?
São organismos que possuem núcleo celular e organelas membranosas.
Falso

São organismos que não possuem núcleo celular, nem organelas membranosas.
Microbiologia: Estrutura bacteriana
A maiorias dos organismos possuem uma molécula circular de DNA de fita _____ (única/dupla).
Dupla.
Microbiologia: Estrutura bacteriana
Esses microorganismos podem apresentar plasmídeos?
Sim.

Microbiologia: Estrutura bacteriana
V ou F?
Todos os procariotos possuem parede celular rígida, exceto os micoplasmas.
Verdadeiro.
Microbiologia: Estrutura bacteriana
Vacúolos são estruturas presentes nesses microorganismos?

Não.
Microbiologia: Estrutura bacteriana
Formas de armazenamento das substâncias de reserva? (3)

- Polímeros de amido e glicogênio ( glicose ) ;
- Ácido-hidroxibutírico;
- Fosfato.
Microbiologia: Estrutura bacteriana
Classificação
Tipos?
- Quanto à forma;
- Quanto ao grau de aglomeração.
Microbiologia: Estrutura bacteriana
Classificação
Quanto à forma? (5)
- Coco;
- Bacilo;
- Vibrião;
- Espirilo;
- Espiroqueta.

Microbiologia: Estrutura bacteriana
Classificação
Quanto ao grau de aglomeração? (6)
- Diplococo;
- Estreptococcos;
- Estafilococcos;
- Sarcina;
- Diplobacilos;
- Estreptobacilos.
Microbiologia: Estrutura bacteriana
Tipos de bactérias capazes de formar colônias?
Bacilos e cocos.
Microbiologia: Estrutura bacteriana
Classificação por nível de aglomeração
Diplococo?
Forma esférica / subesférica e agrupados em pares.

(gênero → diplococos)
Microbiologia: Estrutura bacteriana
Classificação por nível de aglomeração
Estreptococos?
Várias estruturas arredondadas dispostas uma ao lado da outra.

(“colar de pérolas”)
Microbiologia: Estrutura bacteriana
Classificação por nível de aglomeração
Estafilococos?
Cocos organizados em cachos de uva.

Microbiologia: Estrutura bacteriana
Classificação por nível de aglomeração
Sarcina?
Formato cúbico, formado por 4 ou 8 cocos simetricamente postos.

Microbiologia: Estrutura bacteriana
Classificação por nível de aglomeração
Diplobacilos?
Bacilos reunidos dois a dois.

Microbiologia: Estrutura bacteriana
Classificação por nível de aglomeração
Estreptobacilos?
Bacilos alinhados em cadeia.

Microbiologia: Estrutura bacteriana
Principais contribuições das bactérias? (4)
- Produção de alimentos;
- Reciclagem da matéria orgânica;
- Degradação de contaminantes;
- Produção de antibióticos, vitaminas e ácidos orgânicos.
Microbiologia: Estrutura bacteriana
V ou F?
O formato da bactéria depende do formato da sua parede celular.
Verdadeiro.
Microbiologia: Estrutura bacteriana
A parede celular de bactérias gram positivas possui uma espessa camada de proteínas, chamada de…
mureína.
(peptídeoglicano)
Microbiologia: Estrutura bacteriana
As bactérias gram negativas possuem a mesma estrutura que as gram positivas?
Não.
Microbiologia: Estrutura bacteriana
Qual é a principal diferença estrutural das gram negativas para as gram positivas?
Camada de lipídeos externa à camada de mureína (peptídeoglicano).

















